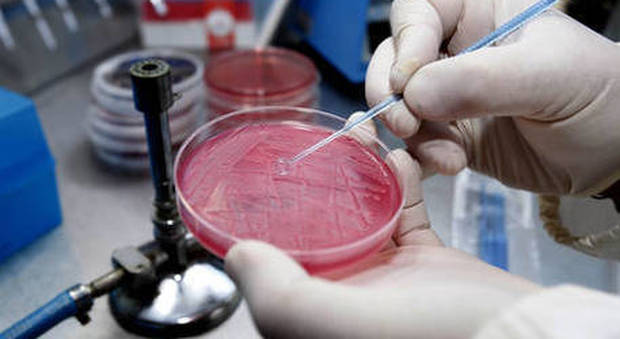

Villa, via del Fosso di Fioranello
680.000 €
Vendita Villa a Roma
VEDI TUTTI GLI ALTRI Vedi tutti gli annunci su ilmessaggerocasa.it

680.000 €
Vendita Villa a Roma
stdClass Object
(
[id] => 2072
[pro_name] => Dott. Thomas Mazzacavallo Psicologo - Psicoterapeuta VICENZA
[published] => 1
[approved] => 1
[agent_id] => 2053
[image] => 207217713700669061fa1971cc3a541da8dbb815fe03b3.jpg
[agent] => stdClass Object
(
[id] => 2053
[agent_type] => 1
[name] => Thomas Mazzacavallo
[alias] => thomas-mazzacavallo
[user_id] => 2734
[company_id] =>
[email] => thomas.mazzacavallo@gmail.com
[address] => Via Petrarca 37
[city] => 7878
[state] => 156
[country] => 92
[photo] => _695f990ea77be.jpg
[ordering] => 0
[published] => 1
[featured] => 0
[request_to_approval] => 0
[nome] => Thomas
[cognome] => Mazzacavallo
[sesso] => 1
[medico_prof] => 0
[titoli] => Psicologo - Psicoterapeuta
[esperienze] => Sono il Dott. Thomas Mazzacavallo, Psicologo Psicoterapeuta ad orientamento Psicodinamico e Psicodrammatista, iscritto all’Ordine degli Psicologi del Veneto con il numero 9025. La mia predisposizione innata per l’ascolto attento e rispettoso delle persone si è evoluta nel tempo in passione autentica per la Psicologia: ho così avuto modo di farla diventare il mio mestiere a partire dagli studi a Padova, dove mi sono laureato in Psicologia Clinico-Dinamica con il massimo dei voti.
Ho avuto l’opportunità di accumulare una vasta esperienza attraverso collaborazioni con diverse realtà, come “S.O.S. Bambino International Adoption”, il Consultorio Familiare dell’AULSS 7 Pedemontana di Thiene e il “Villaggio SOS” di Vicenza. Queste esperienze mi hanno permesso di lavorare con famiglie e minori in situazioni delicate, aiutandomi a comprendere le sfide e le dinamiche che possono influenzare il benessere psicologico.
Dopo la mia Specializzazione in Psicoterapia presso l’Istituto “Mosaico Psicologie” di Bologna con il massimo dei voti e la lode, ho continuato a lavorare in contesti significativi, come la Comunità Alloggio “Il Roveto” di Montecchio Maggiore (VI) e il “Centro Adolescenza” dell’AULSS 7 Pedemontana di Bassano del Grappa (VI). Qui, ho potuto approfondire le mie competenze nel supportare persone adulte con disturbi psichici e affrontare le difficoltà adolescenziali prima che diventino problematiche più gravi.
Sono stato lo Psicologo Supervisore per la Cooperativa Sociale “Eurotrend”, lavorando con gli educatori e le educatrici che si occupano dei Servizi Socio-Educativi con i minori del Comune di Vicenza. Sono, infine, lo Psicologo referente dell’area adolescenti e adulti del territorio di Camisano Vicentino per il Consultorio Familiare “Rezzara” di Vicenza.
Ricevo privatamente e su appuntamento nei miei studi di Vicenza, Breganze e Thiene.
[pubblicazioni] =>
[congressi] =>
[corsi] =>
[attivita] =>
[ordine] =>
[altro] =>
[mostra_indirizzo] => 0
)
)
stdClass Object
(
[id] => 302
[pro_name] => Dottoressa Monica Cappello - Psicologa - Sessuologa TORINO
[published] => 1
[approved] => 1
[agent_id] => 502
[image] => Dottssa-MONICA-CAPPELLO-Psicologa-Sessuologa-Torino.jpg
[agent] => stdClass Object
(
[id] => 502
[agent_type] => 1
[name] => Dr.ssa Monica Cappello
[alias] => dr-ssa-monica-cappello
[user_id] => 502
[company_id] =>
[email] =>
[address] => Via Piffetti 33/C
[city] => 5485
[state] => 144
[country] => 92
[photo] => dr.ssamonica-cappello-torino.jpg
[ordering] => 0
[published] => 1
[featured] => 0
[request_to_approval] => 0
[nome] => Dr.ssa Monica
[cognome] => Cappello
[sesso] => 2
[medico_prof] => 0
[titoli] => 2004 - Diploma di Consulente in Sessuologia, Scuola Superiore di Sessuologia Clinica di Torino 2002 - Iscrizione alll' Ordine degli Psicologi del Piemonte, n°. 3349 2001 - Abilitazione alla Professione di Psicologo 1999 - Laurea In Psicologia con indirizzo di Psicologia Clinica di Comunita', Universita' degli Studi di Torino
[esperienze] => PSICOLOGA e CONSULENTE IN SESSUOLOGIA presso il CENTRO MEDICO PIFFETTI e POLIAMBULATORIO CEMUR 87 e la FARMACIA LUCENTE - TORINO
Collaboratice del sito LA STAMPA.it, sezione SALUTE, per video-interviste di SESSUOLOGIA
Collaboratrice del sito DIARIODELWEB.it, per video-interviste su tematiche sessuologiche
Autrice di articoli su MEDICITALIA.it e GLOBE TODAY'S.it
Membro del Comitato Scientifico della rivista mensile TOP SALUTE, autrice di articoli di Sessuologia e responsabile della Rubrica ESPERTO RISPONDE
Collaboratrice della Rivista settimanale VIVERSANI E BELLI
Ospite in trasmissioni TV su PRIMANTENNA
CONSULENZE SIA INDIVIDUALI CHE DI COPPIA PER PROBLEMATICHE QUALI : DIFFICOLTA' RELAZIONALI E AFFETTIVE DISTURBI SESSUALI (DEFICIT ERETTIVO, EIACULAZIONE PRECOCE, VAGINISMO, DISPAREUNIA, CALO DEL DESIDERIO, ANORGASMIA) DISTURBI DELL'IDENTITA' DI GENERE (DIG) DISTURBI D'ANSIA, ATTACCHI DI PANICO E FOBIE DISTURBO OSSESSIVO - COMPULSIVO
Per appuntamento e informazioni: TEL. 3397712301
Sito web: https://monicacappello-sessuologatorino.business.site/
[pubblicazioni] => Monica Cappello - VITA AFFETTIVA E SESSUALE NEI PARAPLEGICI - Gruppo Editoriale L'Espresso - Dicembre 2015
Monica Cappello - BREVI RACCONTI EROTICI - Gruppo Editoriale L'Espresso - Giugno 2016
[congressi] =>
[corsi] => Corso di formazione per tutor borsisti nell’ambito del progetto “Il Bandolo”, presso la Compagnia di San Paolo
Ciclo di workshop di psicodramma “Figli e genitori: scenari culturali ed emergenze”, presso Ordine degli Psicologi
Corso di formazione su sessualità, gravidanza ed aborto, presso il Centro di aiuto alla vita
Corso di formazione “Donne in difficoltà…come aiutarle”, presso V.S.S.P. (Centro Servizi per il Volontariato Sviluppo e Solidarietà in Piemonte)
Corso di formazione “Prostituzione e tratta delle persone”, presso il Gruppo Abele
Corso di formazione per volontari in ambito psichiatrico, presso la DI.A.PSI
[attivita] => Formatrice in corsi sulla COMUNICAZIONE E I RAPPORTI INTERPERSONALI, SINDROME DEL BURN-OUT, QUALITA' DELLA RELAZIONE NELLE PROFESSIONI D'AIUTO, SESSUALITA' NEI DISABILI...
[ordine] => ORDINE PSICOLOGI DEL PIEMONTE n. 3349
[altro] => Specialista in Sessuologia per ROSSO LIMONE s.r.l., azienda italiana che promuove il benessere sessuale femminile e di coppia.
[mostra_indirizzo] => 1
)
)
stdClass Object
(
[id] => 694
[pro_name] => Dott.ssa Giorgia Antoni Nutrizionista
[published] => 1
[approved] => 1
[agent_id] => 884
[image] => 6941767871443f99864f3c808cd584488e9904d13dac4.jpg
[agent] => stdClass Object
(
[id] => 884
[agent_type] => 1
[name] => Giorgia Antoni
[alias] => giorgia-antoni
[user_id] => 884
[company_id] =>
[email] =>
[address] => Via Milano 1/b
[city] => 6054
[state] => 69
[country] => 92
[photo] => _695f937e0793a.jpg
[ordering] => 0
[published] => 1
[featured] => 0
[request_to_approval] => 0
[nome] => Giorgia
[cognome] => Antoni
[sesso] => 2
[medico_prof] => 0
[titoli] => Dott.ssa Giorgia Antoni Biologa Specialista in Scienza dell'Alimentazione
[esperienze] =>
[pubblicazioni] =>
[congressi] =>
[corsi] =>
[attivita] =>
[ordine] =>
[altro] => Biologa Nutrizionista - Specialista in Scienza dell'Alimentazione - Libero Professionista
Studi di Nutrizione:
CAGLIARI Via Milano, 1/b
IGLESIAS Via Venezia, 60 c/o Poliambulatorio SUD
[mostra_indirizzo] => 1
)
)
stdClass Object
(
[id] => 695
[pro_name] => Dott.ssa Giorgia Antoni Nutrizionista
[published] => 1
[approved] => 1
[agent_id] => 884
[image] => 6951767871301f99864f3c808cd584488e9904d13dac4.jpg
[agent] => stdClass Object
(
[id] => 884
[agent_type] => 1
[name] => Giorgia Antoni
[alias] => giorgia-antoni
[user_id] => 884
[company_id] =>
[email] =>
[address] => Via Milano 1/b
[city] => 6054
[state] => 69
[country] => 92
[photo] => _695f937e0793a.jpg
[ordering] => 0
[published] => 1
[featured] => 0
[request_to_approval] => 0
[nome] => Giorgia
[cognome] => Antoni
[sesso] => 2
[medico_prof] => 0
[titoli] => Dott.ssa Giorgia Antoni Biologa Specialista in Scienza dell'Alimentazione
[esperienze] =>
[pubblicazioni] =>
[congressi] =>
[corsi] =>
[attivita] =>
[ordine] =>
[altro] => Biologa Nutrizionista - Specialista in Scienza dell'Alimentazione - Libero Professionista
Studi di Nutrizione:
CAGLIARI Via Milano, 1/b
IGLESIAS Via Venezia, 60 c/o Poliambulatorio SUD
[mostra_indirizzo] => 1
)
)
stdClass Object
(
[id] => 2039
[pro_name] => OlosTherapy
[published] => 1
[approved] => 1
[agent_id] => 2010
[image] => Esterno-Studio-OlosTherapy-Gazzada-Varese.jpg
[agent] => stdClass Object
(
[id] => 2010
[agent_type] => 1
[name] => Filippo
[alias] => filippo-olgiati
[user_id] => 2616
[company_id] =>
[email] => info.olostherapy@gmail.com
[address] => Via Roma, 65
[city] => 4038
[state] => 150
[country] => 92
[photo] => filippo-olgiati_gazzadaschianno.jpg
[ordering] => 0
[published] => 1
[featured] => 0
[request_to_approval] => 0
[nome] => Filippo
[cognome] => Olgiati
[sesso] => 1
[medico_prof] => 0
[titoli] => Osteopata D.O., Massoterapista M.C.B., Counselor Professionista.
[esperienze] => Dal 11/2022 (ancora in corso) Apertura proprio Studio professionale di Osteopatia, Massoterapia e Counseling OlosTherapy a Gazzada Schianno (Varese)
Dal 02/2017 (ancora in corso) Osteopata e Massoterapista in collaborazione presso il Centro medico Castiglionese (Castiglione Olona).
Dal 08/2015 (ancora in corso) Osteopata e Massoterapista autonomo
[pubblicazioni] =>
[congressi] =>
[corsi] => Manipolazioni Vetebrali
Deep Tissue (introduzione al metodo Rolfing)
Fibrolisi miofasciale connettivale
Kinesio tape
Posturologia
Olismologia metodo MasCurit
Neuroregolazione interattiva (metodo SCENAR e ENF)
Tecarterapia
[attivita] =>
[ordine] =>
[altro] =>
[mostra_indirizzo] => 1
)
)